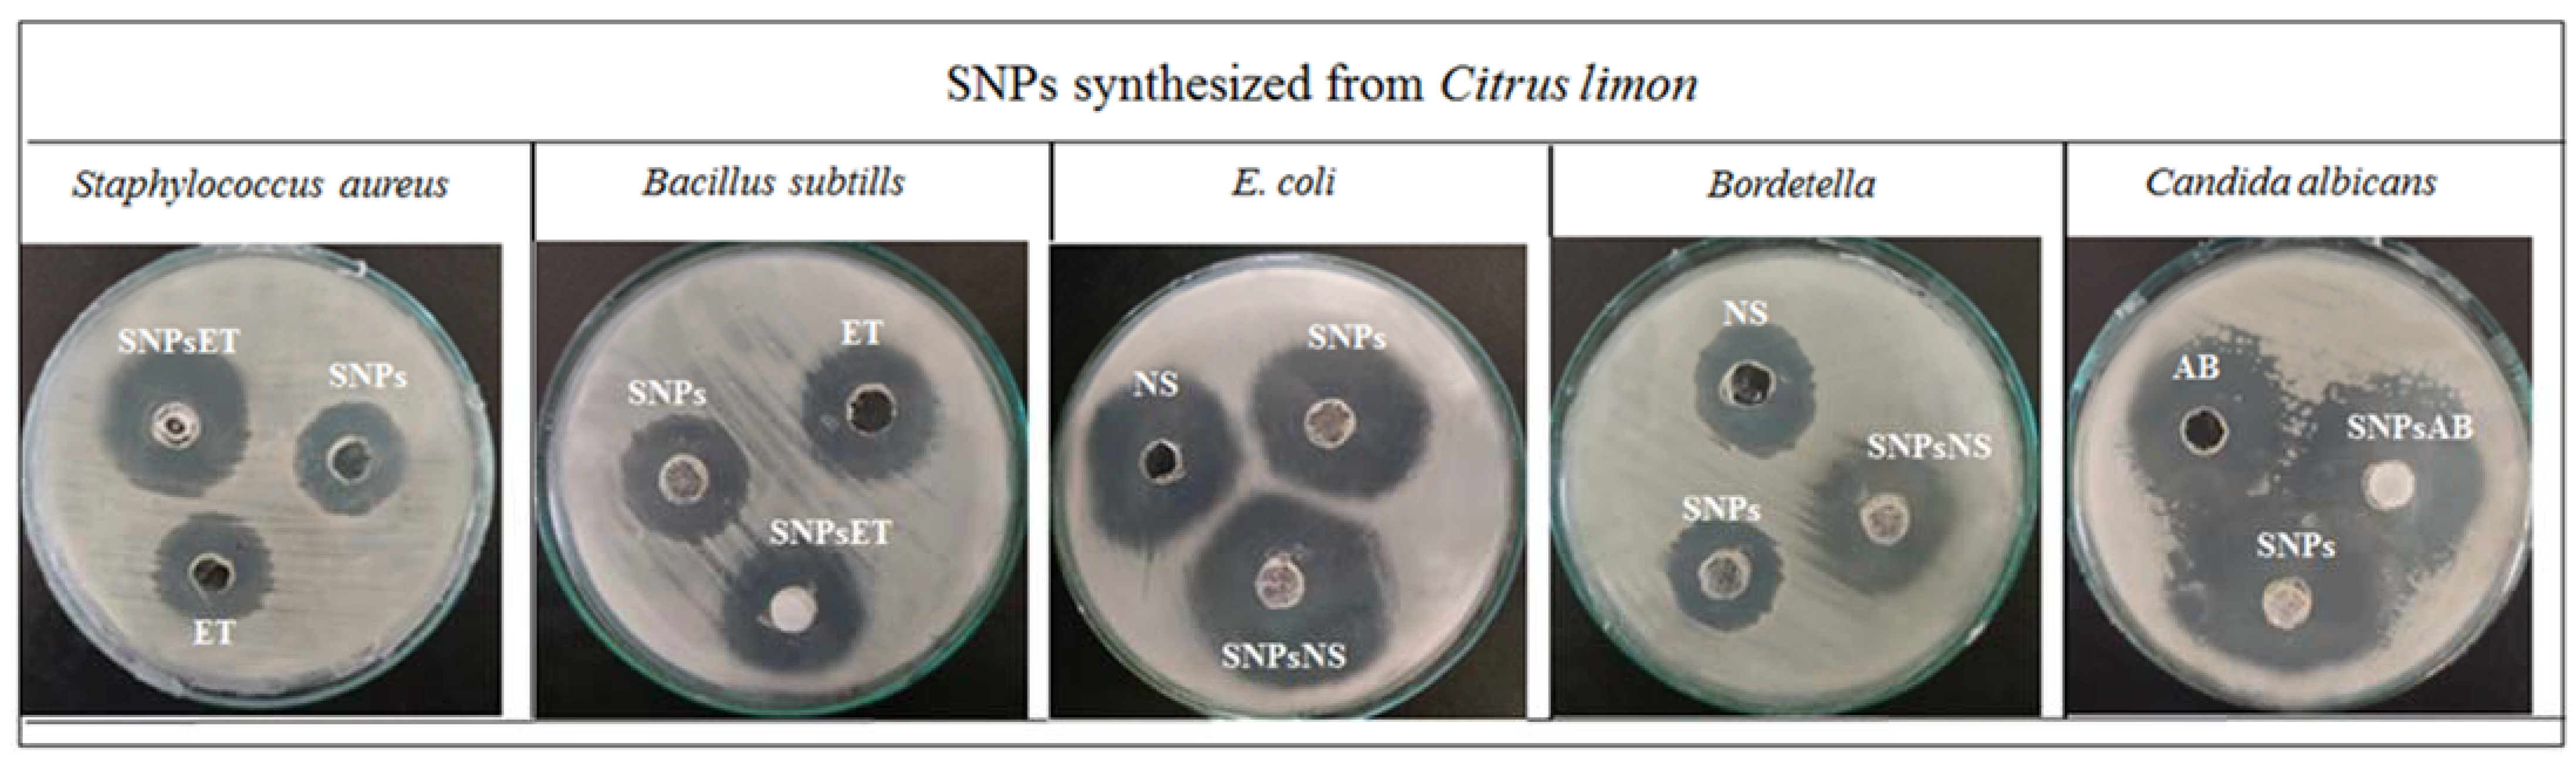

Synthesis and Characterization of Sulfur Nanoparticles of Citrus limon Extract Embedded in Nanohydrogel Formulation: In Vitro and In Vivo Studies
Abstract
1. Introduction
2. Results and Discussion
2.1. Characterization of Synthesized Sulfur Nanoparticles
2.1.1. Particle Size, Polydispersity Index, and Zeta Potential
2.1.2. UV−Visible Spectrophotometer
2.1.3. Scanning Electron Microscopy (SEM)
2.1.4. Attenuated Total Reflectance/Fourier Transform Infrared Spectroscopy (ATR-FTIR)
2.2. In Vitro Studies
Antibacterial and Antifungal Activity
2.3. Characterization of Nanohydrogel
2.3.1. Organoleptic Evaluation of Nanohydrogel
2.3.2. Viscosity of Nanohydrogels
2.4. Skin Irritation Test
2.5. In Vivo Studies
2.6. Stability Test
3. Conclusions
4. Materials and Methods
4.1. Materials
4.2. Plant Extract Formation
4.3. Synthesis of Sulfur Nanoparticles
4.4. Characterization of Synthesized Sulfur Nanoparticles
4.4.1. Particle Size and Zeta Potential
4.4.2. UV–Visible Spectroscopy
4.4.3. ATR-FTIR Analysis
4.4.4. Scanning Electron Microscopy (SEM)
4.5. In Vitro Studies
Antibacterial and Antifungal Analysis
4.6. Formation of Nanohydrogel
4.7. Characterization of Nanohydrogel
4.7.1. pH of Nanohydrogel
4.7.2. Homogeneity Test
4.7.3. Viscosity of Nanohydrogel
4.8. Skin Irritation Test
4.9. In Vivo Studies
4.10. Stability Test
4.11. Statistical Analysis
Author Contributions
Funding
Institutional Review Board Statement
Informed Consent Statement
Data Availability Statement
Acknowledgments
Conflicts of Interest
References
- Sousa, F.; Ferreira, D.; Reis, S.; Costa, P. Current insights on antifungal therapy: Novel nanotechnology approaches for drug delivery systems and new drugs from natural sources. Pharmaceuticals 2020, 13, 248. [Google Scholar] [CrossRef]
- Sahu, T.; Ratre, Y.K.; Chauhan, S.; Bhaskar, L.; Nair, M.P.; Verma, H.K. Nanotechnology based drug delivery system: Current strategies and emerging therapeutic potential for medical science. J. Drug Deliv. Sci. Technol. 2021, 63, 102487. [Google Scholar] [CrossRef]
- Khan, I.; Saeed, K.; Khan, I. Nanoparticles: Properties, applications and toxicities. Arab. J. Chem. 2019, 12, 908–931. [Google Scholar] [CrossRef]
- Uzair, B.; Liaqat, A.; Iqbal, H.; Menaa, B.; Razzaq, A.; Thiripuranathar, G.; Rana, N.F.; Menaa, F. Green and cost-effective synthesis of metallic nanoparticles by algae: Safe methods for translational medicine. Bioengineering 2020, 7, 129. [Google Scholar] [CrossRef]
- Singh, J.; Dutta, T.; Kim, K.-H.; Rawat, M.; Samddar, P.; Kumar, P. ‘Green’synthesis of metals and their oxide nanoparticles: Applications for environmental remediation. J. Nanobiotechnol. 2018, 16, 84. [Google Scholar] [CrossRef]
- Olawale, F.; Oladimeji, O.; Ariatti, M.; Singh, M. Emerging Roles of Green-Synthesized Chalcogen and Chalcogenide Nanoparticles in Cancer Theranostics. J. Nanotechnol. 2022, 2022, 6176610. [Google Scholar] [CrossRef]
- Ahmed, S.F.; Mofijur, M.; Rafa, N.; Chowdhury, A.T.; Chowdhury, S.; Nahrin, M.; Islam, A.S.; Ong, H.C. Green approaches in synthesising nanomaterials for environmental nanobioremediation: Technological advancements, applications, benefits and challenges. Environ. Res. 2022, 204, 111967. [Google Scholar] [CrossRef] [PubMed]
- Singh, A.K. A review on plant extract-based route for synthesis of cobalt nanoparticles: Photocatalytic, electrochemical sensing and antibacterial applications. Curr. Res. Green Sustain. Chem. 2022, 5, 100270. [Google Scholar] [CrossRef]
- Gokoglu, N. Novel natural food preservatives and applications in seafood preservation: A review. J. Sci. Food Agric. 2019, 99, 2068–2077. [Google Scholar] [CrossRef]
- Jubeh, B.; Breijyeh, Z.; Karaman, R. Resistance of gram-positive bacteria to current antibacterial agents and overcoming approaches. Molecules 2020, 25, 2888. [Google Scholar] [CrossRef] [PubMed]
- Hamida, R.S.; Ali, M.A.; Goda, D.A.; Khalil, M.I.; Al-Zaban, M.I. Novel biogenic silver nanoparticle-induced reactive oxygen species inhibit the biofilm formation and virulence activities of methicillin-resistant Staphylococcus aureus (MRSA) strain. Front. Bioeng. Biotechnol. 2020, 8, 433. [Google Scholar] [CrossRef] [PubMed]
- Alexander, M.K.; Miu, A.; Oh, A.; Reichelt, M.; Ho, H.; Chalouni, C.; Labadie, S.; Wang, L.; Liang, J.; Nickerson, N.N.; et al. Disrupting gram-negative bacterial outer membrane biosynthesis through inhibition of the lipopolysaccharide transporter MsbA. Antimicrob. Agents Chemother. 2018, 62, e01142-18. [Google Scholar] [CrossRef] [PubMed]
- Rajeshkumar, S.; Bharath, L.; Geetha, R. Broad spectrum antibacterial silver nanoparticle green synthesis: Characterization, and mechanism of action. In Green Synthesis, Characterization and Applications of Nanoparticles; Elsevier: Amsterdam, The Netherlands, 2019; pp. 429–444. [Google Scholar]
- Priyadarshi, R.; Roy, S.; Ghosh, T.; Biswas, D.; Rhim, J.-W. Antimicrobial nanofillers reinforced biopolymer composite films for active food packaging applications-a review. Sustain. Mater. Technol. 2022, 32, e00353. [Google Scholar] [CrossRef]
- Bhavaniramya, S.; Vishnupriya, S.; Al-Aboody, M.S.; Vijayakumar, R.; Baskaran, D. Role of essential oils in food safety: Antimicrobial and antioxidant applications. Grain Oil Sci. Technol. 2019, 2, 49–55. [Google Scholar] [CrossRef]
- Dadar, M.; Tiwari, R.; Karthik, K.; Chakraborty, S.; Shahali, Y.; Dhama, K. Candida albicans-Biology, molecular characterization; pathogenicity, and advances in diagnosis and control–An update. Microb. Pathog. 2018, 117, 128–138. [Google Scholar] [CrossRef]
- Sharifi-Rad, J.; Sureda, A.; Tenore, G.C.; Daglia, M.; Sharifi-Rad, M.; Valussi, M.; Tundis, R.; Sharifi-Rad, M.; Loizzo, M.R.; Ademiluyi, A.O.; et al. Biological activities of essential oils: From plant chemoecology to traditional healing systems. Molecules 2017, 22, 70. [Google Scholar] [CrossRef] [PubMed]
- Lee, Y.; Puumala, E.; Robbins, N.; Cowen, L.E. Antifungal drug resistance: Molecular mechanisms in Candida albicans and beyond. Chem. Rev. 2020, 121, 3390–3411. [Google Scholar] [CrossRef]
- Lu, L.; Yuan, S.; Wang, J.; Shen, Y.; Deng, S.; Xie, L.; Yang, Q. The formation mechanism of hydrogels. Curr. Stem Cell Res. Ther. 2018, 13, 490–496. [Google Scholar] [CrossRef]
- Akram, M.; Hussain, R. Nanohydrogels: History, development, and applications in drug delivery. In Nanocellulose and Nanohydrogel Matrices: Biotechnological and Biomedical Applications; John Wiley & Sons, Inc.: Hoboken, NJ, USA, 2017; pp. 297–330. [Google Scholar]
- Prasathkumar, M.; Sadhasivam, S. Chitosan/Hyaluronic acid/Alginate and an assorted polymers loaded with honey, plant, and marine compounds for progressive wound healing—Know-how. Int. J. Biol. Macromol. 2021, 186, 656–685. [Google Scholar] [CrossRef]
- Kotcherlakota, R.; Das, S.; Patra, C.R. Therapeutic applications of green-synthesized silver nanoparticles. In Green Synthesis, Characterization and Applications of Nanoparticles; Elsevier: Amsterdam, The Netherlands, 2019; pp. 389–428. [Google Scholar]
- Paralikar, P.; Rai, M. Bio-inspired synthesis of sulphur nanoparticles using leaf extract of four medicinal plants with special reference to their antibacterial activity. IET Nanobiotechnol. 2018, 12, 25–31. [Google Scholar] [CrossRef]
- Tripathi, R.; Rao, R.; Tsuzuki, T. Green synthesis of sulfur nanoparticles and evaluation of their catalytic detoxification of hexavalent chromium in water. RSC Adv. 2018, 8, 36345–36352. [Google Scholar] [CrossRef] [PubMed]
- Kumar, I.; Mondal, M.; Sakthivel, N. Green synthesis of phytogenic nanoparticles. In Green Synthesis, Characterization and Applications of Nanoparticles; Elsevier: Amsterdam, The Netherlands, 2019; pp. 37–73. [Google Scholar]
- Raja, S.; Ramesh, V.; Thivaharan, V. Antibacterial and anticoagulant activity of silver nanoparticles synthesised from a novel source–pods of Peltophorum pterocarpum. J. Ind. Eng. Chem. 2015, 29, 257–264. [Google Scholar] [CrossRef]
- Jaiswal, L.; Shankar, S.; Rhim, J.-W. Carrageenan-based functional hydrogel film reinforced with sulfur nanoparticles and grapefruit seed extract for wound healing application. Carbohydr. Polym. 2019, 224, 115191. [Google Scholar] [CrossRef] [PubMed]
- Ijaz, N.; Rehman, Z.U.; Ijaz, Z. Principles and prospects of using lignosulphonate as a sustainable expansive soil ameliorator: From basics to innovations. In Advances in Sustainable Materials and Resilient Infrastructure; Springer: Berlin/Heidelberg, Germany, 2022; pp. 103–116. [Google Scholar]
- Krambeck, K.; Silva, V.; Silva, R.; Fernandes, C.; Cagide, F.; Borges, F.; Santos, D.; Otero-Espinar, F.; Lobo, J.M.S.; Amaral, M.H. Design and characterization of Nanostructured lipid carriers (NLC) and Nanostructured lipid carrier-based hydrogels containing Passiflora edulis seeds oil. Int. J. Pharm. 2021, 600, 120444. [Google Scholar] [CrossRef]
- Cacopardo, L.; Guazzelli, N.; Nossa, R.; Mattei, G.; Ahluwalia, A. Engineering hydrogel viscoelasticity. J. Mech. Behav. Biomed. Mater. 2019, 89, 162–167. [Google Scholar] [CrossRef]
- Kumar, S.; Prasad, M.; Rao, R. Topical delivery of clobetasol propionate loaded nanosponge hydrogel for effective treatment of psoriasis: Formulation, physicochemical characterization, antipsoriatic potential and biochemical estimation. Mater. Sci. Eng. C 2021, 119, 111605. [Google Scholar] [CrossRef]
- Ghica, M.V.; Hîrjău, M.; Lupuleasa, D.; Dinu-Pîrvu, C.-E. Flow and thixotropic parameters for rheological characterization of hydrogels. Molecules 2016, 21, 786. [Google Scholar] [CrossRef]
- Akhavan, A.; Bershad, S. Topical acne drugs: Review of clinical properties, systemic exposure, and safety. Am. J. Clin. Dermatol. 2003, 4, 473–492. [Google Scholar] [CrossRef]
- Rafique, S.; Hassan, S.; Mughal, S.; Hassan, S.; Shabbir, N.; Perveiz, S.; Mushtaq, M.; Farman, M. Biological attributes of lemon: A review. J. Addict. Med. Ther. Sci. 2020, 6, 030–034. [Google Scholar]
- Hosseini, M.; Jamshidi, A.; Raeisi, M.; Azizzadeh, M. Effect of sodium alginate coating containing clove (Syzygium aromaticum) and lemon verbena (Aloysia Citriodora) essential oils and different packaging treatments on shelf life extension of refrigerated chicken breast. J. Food Process. Preserv. 2021, 45, e14946. [Google Scholar] [CrossRef]
- Valizadeh, A.; Shirzad, M.; Pourmand, M.R.; Farahmandfar, M.; Sereshti, H.; Amani, A. Preparation and comparison of effects of different herbal oil ointments as wound-healing agents. Cells Tissues Organs 2019, 207, 177–186. [Google Scholar] [CrossRef] [PubMed]
- Sevinç-Özakar, R.; Seyret, E.; Özakar, E.; Adıgüzel, M.C. Nanoemulsion-Based Hydrogels and Organogels Containing Propolis and Dexpanthenol: Preparation, Characterization, and Comparative Evaluation of Stability, Antimicrobial, and Cytotoxic Properties. Gels 2022, 8, 578. [Google Scholar] [CrossRef] [PubMed]
- Miastkowska, M.; Kulawik-Pióro, A.; Szczurek, M. Nanoemulsion gel formulation optimization for burn wounds: Analysis of rheological and sensory properties. Processes 2020, 8, 1416. [Google Scholar] [CrossRef]
- Ehiobu, J.; Idamokoro, M.; Afolayan, A. Phytochemical content and antioxidant potential of leaf extracts of Citrus limon (L.) Osbeck collected in the Eastern Cape Province, South Africa. S. Afr. J. Bot. 2021, 141, 480–486. [Google Scholar] [CrossRef]
- Khairan, K.; Hasan, M.; Idroes, R.; Diah, M. Fabrication and Evaluation of Polyvinyl Alcohol/Corn Starch/Patchouli Oil Hydrogel Films Loaded with Silver Nanoparticles Biosynthesized in Pogostemon cablin Benth Leaves’ Extract. Molecules 2023, 28, 2020. [Google Scholar] [CrossRef] [PubMed]
- Khane, Y.; Benouis, K.; Albukhaty, S.; Sulaiman, G.M.; Abomughaid, M.M.; Al Ali, A.; Aouf, D.; Fenniche, F.; Khane, S.; Chaibi, W.; et al. Green synthesis of silver nanoparticles using aqueous Citrus limon zest extract: Characterization and evaluation of their antioxidant and antimicrobial properties. Nanomaterials 2022, 12, 2013. [Google Scholar] [CrossRef]
- Thakur, S.; Das, G.; Raul, K.; Karak, N. Green one-step approach to prepare sulfur/reduced graphene oxide nanohybrid for effective mercury ions removal. J. Phys. Chem. C 2013, 117, 7636–7642. [Google Scholar] [CrossRef]
- Edison, T.N.J.I.; Atchudan, R.; Sethuraman, M.G.; Shim, J.-J.; Lee, Y.R. Microwave assisted green synthesis of fluorescent N-doped carbon dots: Cytotoxicity and bio-imaging applications. J. Photochem. Photobiol. B Biol. 2016, 161, 154–161. [Google Scholar] [CrossRef]
- Vijayan, R.; Joseph, S.; Mathew, B. Indigofera tinctoria leaf extract mediated green synthesis of silver and gold nanoparticles and assessment of their anticancer, antimicrobial, antioxidant and catalytic properties. Artif. Cells Nanomed. Biotechnol. 2018, 46, 861–871. [Google Scholar] [CrossRef]
- Gupta, S.; Gupta, J.; Anand, A.; Ojha, S. Review on nanogel/emulgel formulations of traditional medicines. Biol. Sci. 2022, 2, 269–278. [Google Scholar] [CrossRef]
- Bourbon, A.I.; Pinheiro, A.C.; Carneiro-da-Cunha, M.G.; Pereira, R.N.; Cerqueira, M.A.; Vicente, A.A. Development and characterization of lactoferrin-GMP nanohydrogels: Evaluation of pH, ionic strength and temperature effect. Food Hydrocoll. 2015, 48, 292–300. [Google Scholar] [CrossRef]
- Bi, S.; Feng, C.; Wang, M.; Kong, M.; Liu, Y.; Cheng, X.; Wang, X.; Chen, X. Temperature responsive self-assembled hydroxybutyl chitosan nanohydrogel based on homogeneous reaction for smart window. Carbohydr. Polym. 2020, 229, 115557. [Google Scholar] [CrossRef] [PubMed]
- Moraes, R.R.; Garcia, J.W.; Barros, M.D.; Lewis, S.H.; Pfeifer, C.S.; Liu, J.; Stansbury, J.W. Control of polymerization shrinkage and stress in nanogel-modified monomer and composite materials. Dent. Mater. 2011, 27, 509–519. [Google Scholar] [CrossRef]
- Latif, M.S.; Nawaz, A.; Asmari, M.; Uddin, J.; Ullah, H.; Ahmad, S. Formulation Development and In Vitro/In Vivo Characterization of Methotrexate-Loaded Nanoemulsion Gel Formulations for Enhanced Topical Delivery. Gels 2023, 9, 3. [Google Scholar] [CrossRef] [PubMed]
- Kostrzębska, A.; Pączek, K.; Weselak, A.; Musiał, W. Effect of hydrogel substrate components on the stability of tetracycline hydrochloride and swelling activity against model skin sebum. Int. J. Mol. Sci. 2023, 24, 2678. [Google Scholar] [CrossRef] [PubMed]

| F. Code | pH | Odor | Color | Phase Separation | Homogeneity | Consistency |
|---|---|---|---|---|---|---|
| NHGF4 | 5.5 ± 0.63 | Very Good | Off−white | Nil | Excellent | Very Good |
| Parameters | Temperature | |
|---|---|---|
| 4 ± 2 °C | 40 ± 2 °C | |
| Odor | No change | No change |
| Color | Off white | Off white |
| Phase separation | Nil | Nil |
| Homogeneity | Excellent | Excellent |
| Consistency | Very Good | Very Good |
| S. No | Ingredients | F1 (g) | F2 (g) | F3 (g) | F4 (g) | F5 (g) |
|---|---|---|---|---|---|---|
| 1 | Carbopol-934 | 19 | 15 | 10 | 8.5 | 5 |
| 2 | Distilled water | 80 | 83 | 87.5 | 90 | 92 |
| 3 | Triethanolamine (TEA) | 1 | 2 | 2.5 | 1.5 | 3 |
| 4 | Total | 100 | 100 | 100 | 100 | 100 |
| S. No | Ingredients | Nanoparticle Loaded Nanohydrogel (NHGF4) |
|---|---|---|
| 1 | Sulfur nanoparticles (Citrus limon) | 5 g |
| 2 | Carbopol-934 | 8.5 g |
| 3 | Distilled water | 85 g |
| 4 | Triethanolamine (TEA) | 1.5 g |
Disclaimer/Publisher’s Note: The statements, opinions and data contained in all publications are solely those of the individual author(s) and contributor(s) and not of MDPI and/or the editor(s). MDPI and/or the editor(s) disclaim responsibility for any injury to people or property resulting from any ideas, methods, instructions or products referred to in the content. |
© 2023 by the authors. Licensee MDPI, Basel, Switzerland. This article is an open access article distributed under the terms and conditions of the Creative Commons Attribution (CC BY) license (https://creativecommons.org/licenses/by/4.0/).
Share and Cite
Baloch, H.; Siddiqua, A.; Nawaz, A.; Latif, M.S.; Zahra, S.Q.; Alomar, S.Y.; Ahmad, N.; Elsayed, T.M. Synthesis and Characterization of Sulfur Nanoparticles of Citrus limon Extract Embedded in Nanohydrogel Formulation: In Vitro and In Vivo Studies. Gels 2023, 9, 284. https://doi.org/10.3390/gels9040284
Baloch H, Siddiqua A, Nawaz A, Latif MS, Zahra SQ, Alomar SY, Ahmad N, Elsayed TM. Synthesis and Characterization of Sulfur Nanoparticles of Citrus limon Extract Embedded in Nanohydrogel Formulation: In Vitro and In Vivo Studies. Gels. 2023; 9(4):284. https://doi.org/10.3390/gels9040284
Chicago/Turabian StyleBaloch, Hadia, Aisha Siddiqua, Asif Nawaz, Muhammad Shahid Latif, Syeda Qurbat Zahra, Suliman Yousef Alomar, Naushad Ahmad, and Tarek M. Elsayed. 2023. "Synthesis and Characterization of Sulfur Nanoparticles of Citrus limon Extract Embedded in Nanohydrogel Formulation: In Vitro and In Vivo Studies" Gels 9, no. 4: 284. https://doi.org/10.3390/gels9040284
APA StyleBaloch, H., Siddiqua, A., Nawaz, A., Latif, M. S., Zahra, S. Q., Alomar, S. Y., Ahmad, N., & Elsayed, T. M. (2023). Synthesis and Characterization of Sulfur Nanoparticles of Citrus limon Extract Embedded in Nanohydrogel Formulation: In Vitro and In Vivo Studies. Gels, 9(4), 284. https://doi.org/10.3390/gels9040284

